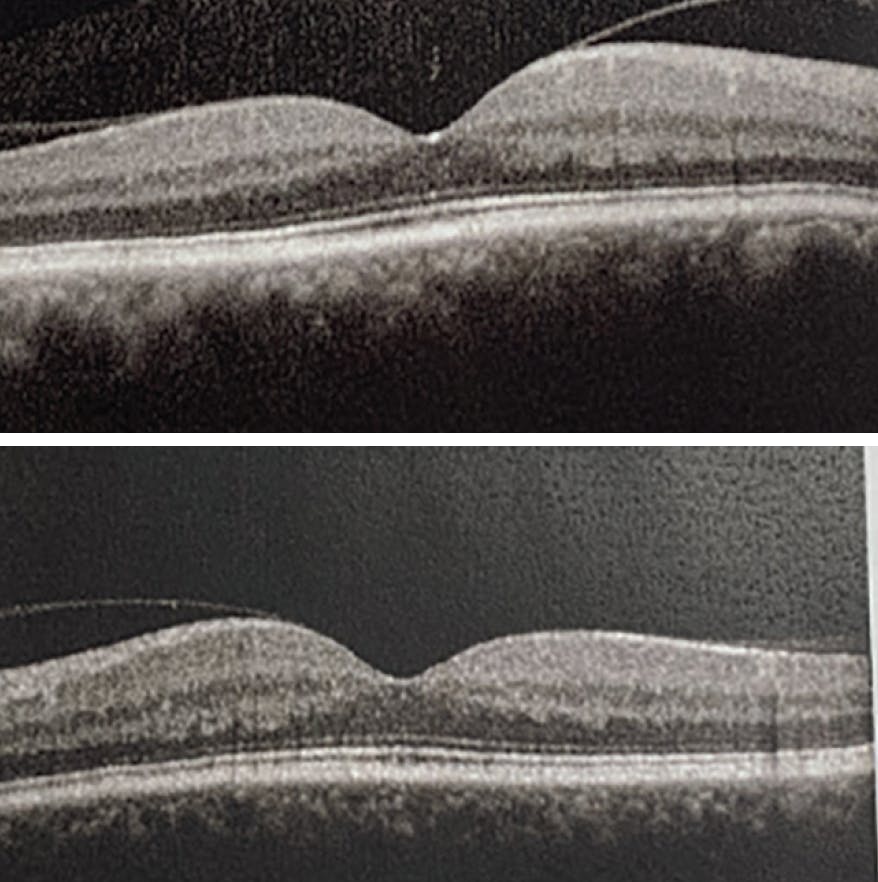
<p>Figure 5. Two months after resuming paclitaxel, there was no return of CME in either eye while the patient used prophylactic dorzolamide drops TID.</p>

A 61-year-old White man presented with complaints of blurry vision in both eyes with gradual onset over approximately 1 month. He was referred to the retina service after a cataract evaluation, during which his cataracts were deemed not visually significant. His medical history was notable for stage 4 pancreatic cancer, insulin-dependent diabetes, hypertension, and heart valve disease.
BCVA on initial presentation was 20/150 OD and 20/80 OS. Pupils, motility, confrontational fields, and IOP were within normal limits. Examination of the posterior segment revealed blunted foveal light reflex in each eye, but was otherwise unremarkable, without evidence of diabetic retinopathy (Figure 1). OCT showed severe cystoid macular edema (CME) in each eye (Figure 2). Fluorescein angiography did not reveal any evidence of leakage or neovascularization in either eye (Figure 3).

Figure 1. Fundus imaging did not demonstrate any evidence of diabetic retinopathy or other vascular abnormality. The white spots represent artifact from the camera.

Figure 3. Fluorescein angiography did not show evidence of vascular leakage or neovascularization in either eye.
Differential Diagnosis
The differential diagnosis for CME without leakage includes nicotinic acid maculopathy, Goldmann-Favre syndrome, X-linked retinoschisis, retinitis pigmentosa, and toxicity from antimicrotubule (ie, taxane) chemotherapy agents. This patient was undergoing chemotherapy with paclitaxel (Abraxane, Bristol Myers Squibb), a microtubule inhibitor that is used to treat malignancies such as breast and pancreatic cancer, which was determined to be the cause of the CME.
Management and Clinical Course
After communicating with the patient’s oncologist, paclitaxel was discontinued; he remained on his other chemotherapy agent, gemcitabine. The referring ophthalmologist had prescribed prednisolone acetate and ketorolac drops for several weeks prior to his appointment with the retina service. While OCT showed modest improvement after starting the drops, this change coincided with discontinuation of paclitaxel, so it is unclear how much each intervention affected the CME. Dorzolamide drops were also prescribed.
One month later, the CME had nearly resolved in each eye. VA improved substantially to 20/80 OD and 20/60 OS (Figure 4). He was gradually tapered off all drops without any recurrence of CME for the next 5 months of follow-up. About 6 months after his initial presentation, the paclitaxel was restarted by his oncologist at half of the original dose due to poor control of his pancreatic cancer. Dorzolamide drops were resumed as prophylaxis, and there was no return of CME over the next 3 months of follow-up. On his final visit, VA was 20/40 OD and 20/30 OS. The patient passed away in September 2021.
PATHOPHYSIOLOGY
Ophthalmological side effects of taxane agents, such as paclitaxel, have been reported in 10% of patients using this medication; a decrease in visual acuity occurs in 4%.1 Taxanes disrupt the microtubule network within cells that is essential for mitosis, ultimately resulting in cell death. While the pathophysiology of taxane-associated CME is not completely understood, it has been proposed that toxicity of Müller cells, which play a role in dehydrating the macula by metabolic pumps, leads to the accumulation of fluid.2
TREATMENT
There are no recommended treatment guidelines for this condition because of the unclear pathology; however, there is often resolution of CME and improvement in visual acuity after discontinuation of the causative agent.3 The decision to stop a chemotherapy agent must be weighed carefully in collaboration with the patient and their oncologist, including discussion of the potential effect on the patient’s prognosis and quality of life.
Taxane-associated CME has not been shown to respond well to monthly bevacizumab (Avastin, Genentech/Roche) injections, suggesting that VEGF does not play a role in the pathogenesis.2 Corticosteroids are a common approach to treating CME of various etiologies. In one case report, sub-Tenon triamcinolone injection had minimal effect on CME, while cessation of a taxane agent was required for complete resolution.4 In another study, a dexamethasone intravitreal implant (Ozurdex, Allergan/AbbVie) resulted in improvement of CME after 1 month while the patient continued taking the taxane agent, but CME did not completely resolve until 2 months after cessation of the agent.5 Thus, it is possible that ocular corticosteroids could have an adjuvant role in treating CME in these patients, especially if cessation of the taxane agent is not feasible; however, they are unlikely to result in complete resolution of taxane-associated CME.
Carbonic anhydrase inhibitors have been shown to be effective in treating CME associated with retinitis pigmentosa and have also been used for taxane-associated CME.6,7 One case report showed that dorzolamide drops helped to resolve CME after inadequate response to cessation of paclitaxel alone.8 Oral methazolamide was reported to prevent progression of CME and severe vision loss in the case of a Korean patient who continued paclitaxel therapy in spite of maculopathy, although the methazolamide did not completely resolve the CME.9 In another case report, oral acetazolamide was shown to induce rapid improvement of visual acuity and complete regression of CME after 8 weeks, despite continued chemotherapy.10
In our case, the patient was treated with prednisolone, ketorolac, and dorzolamide drops, but because the improvement coincided with the cessation of the paclitaxel, we cannot determine whether there was any benefit from these topical therapies. There is no clinical trial that compares cessation of the taxane alone versus cessation of the taxane combined with carbonic anhydrase inhibitors or antiinflammatory medication. It is also unclear whether prophylactic dorzolamide drops helped to prevent recurrence of CME in this patient when he resumed paclitaxel at half dose in the last few months of his life.
Figure 5. Two months after resuming paclitaxel, there was no return of CME in either eye while the patient used prophylactic dorzolamide drops TID.
CLINCAL IMPLICATIONS
Patients receiving chemotherapy with microtubule-inhibiting taxane agents are susceptible to developing a form of angiographically silent CME. While the mechanism is not completely understood, Müller cell toxicity may play a role. CME typically resolves with cessation of the taxane agent, a decision that must be discussed with the patient and their oncologist. Several case reports support the use of oral or topical carbonic anhydrase inhibitors (and perhaps ocular corticosteroids to a lesser degree) as adjuvant treatment options if a patient must continue with taxane chemotherapy agents, but further research on these treatment approaches is warranted.
1. Noguchi Y, Kawashima Y, Maruyama M. Risk factors for eye disorders caused by paclitaxel: a retrospective study. Biol Pharm Bull. 2018;41(11):1694-1700.
2. Rahman HT, Yeh S, Bergstrom CS. Cystoid macular edema without leakage secondary to nab-Paclitaxel (Abraxane): clinical experience with intravitreal bevacizumab. J Ocul Pharmacol Ther. 2013;29(3):360-362.
3. Kuznetcova TI, Cech P, Herbort CP. The mystery of angiographically silent macular oedema due to taxanes. Int Ophthalmol. 2012;32(3):299-304.
4. Matsuoka N, Hasebe H, Mayama T, Fukuchi T. Sub-tenon injections of triamcinolone acetonide had limited effect on cystoid macular edema secondary to nanoparticle albumin-bound-paclitaxel (Abraxane). Case Rep Ophthalmol Med. 2015;2015:181269.
5. Burgos-Blasco B, Hernandez-Ruiz S, Lopez-Guajardo L, Donate-Lopez J. Dexamethasone intravitreal implant in cystoid macular edema secondary to paclitaxel therapy. Am J Ophthalmol Case Rep. 2020;18:100653.
6. Fishman GA, Apushkin MA. Continued use of dorzolamide for the treatment of cystoid macular oedema in patients with retinitis pigmentosa. Br J Ophthalmol. 2007;91(6):743-745.
7. Grover S, Apushkin MA, Fishman GA. Topical dorzolamide for the treatment of cystoid macular edema in patients with retinitis pigmentosa. Am J Ophthalmol. 2006;141(5):850-858.
8. Dwivedi R, Tiroumal S. Possible efficacy of topical dorzolamide in the treatment of paclitaxel-related cystoid edema. Retin Cases Brief Rep. 2018;12(1):75-79.
9. Koo NK, Kim YC. A case of paclitaxel-induced maculopathy treated with methazolamide. Korean J Ophthalmol. 2012;26(5):394-397.
10. Meyer KM, Klink T, Ugurel S, Bröcker EB. Regression of paclitaxel-induced maculopathy with oral acetazolamide. Graefes Arch Clin Exp Ophthalmol. 2012;250(3):463-464.

























